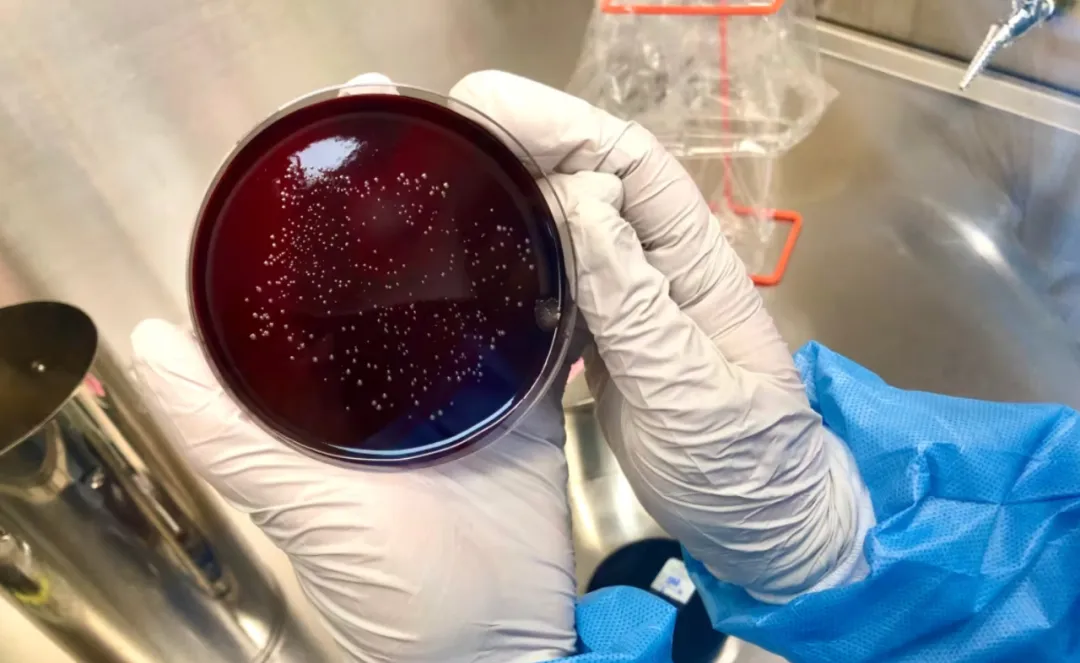
图片

百日咳的典型声音刺耳且清晰易懂:患者呼吸困难时,会发出刺耳、深沉的干咳声,并伴有独特的“呼呼声”。
这不是任何人都想感染的疾病,尤其是对于脆弱人群来说,它可能会致命。

加拿大百日咳病例增加
最近在加拿大,感染该病的人数(主要是儿童和青少年)正在飙升到惊人的水平。
加拿大公共卫生署 (PHAC) 援引全国各地媒体报道,向 CBC 新闻表示,截至 2024 年迄今为止,已报告百日咳病例超过 12,000 例。这远远高于每年通常报告的全国感染病例约 500 至 4,500 例。
百日咳是由一种名为百日咳杆菌的细菌引起的,今年绝大多数百日咳病例发生在魁北克省,不过近几个月来其他各省也开始出现疫情或病例数量高于往常。
PHAC 发言人在一份声明中表示:“尽管在新冠疫情期间百日咳活动量创下历史新低后,预计百日咳活动量会增加……但 2024 年魁北克省、安省、新不伦瑞克省、爱德华王子岛和纽芬兰和拉布拉多省的病例数将超过疫情前的高峰期。”
省级仪表板显示,截至 6 月,安大略省已发现 470 例百日咳病例,而五年平均值为 98 例。今年迄今为止,多伦多已报告了 99 例病例,而渥太华已报告了 76 例病例,是这两个城市疫情前年平均病例数的两倍多。

感染人数的大幅增加与去年美国和欧洲的趋势相似。熟悉百日咳的科学家表示,感染人数的激增是由多种因素共同造成的,形成了一场严重的风暴,使社会上最年轻的人面临患上严重疾病的风险。
加拿大哈利法克斯疫苗学中心实验室管理副主任、临床科学家梅·埃尔谢里夫博士说:“考虑到百日咳的周期性,我认为发生这种事并不令人意外,但令人意外的是其严重程度和规模。”

百日咳患者大多数年龄在 10 至 14 岁之间。该病毒传染性极强,虽然许多人的症状可能很轻微,但感染也可能导致肺炎、脑损伤或危及生命的疾病。
“百日咳不仅仅是维多利亚时代小说中才会出现的疾病。现在人们仍然会患上这种病,而且会造成严重的损害。”传染病专家、位于 Baltimore 的 约翰霍普金斯大学健康安全中心(Johns Hopkins Center for Health Security)高级学者 Dr. Amesh Adalja 说道。
“成年人经常会因为咳嗽太剧烈而导致肋骨断裂。”
但蒙特利尔儿童医院的临床医生和研究员 Dr. Jesse Papenburg 强调称,新生儿,特别是那些尚未接种百日咳疫苗的新生儿,也是病情最严重甚至死亡的人群之一。
他说:“实际上,婴幼儿,尤其是六个月左右的婴儿,发生并发症的风险最高。”
根据欧洲疾病预防控制中心的数据,在欧洲最近爆发的百日咳疫情中,2023 年和 2024 年第一季度共涉及 60,000 多例病例,至少有 8 名老年人和 11 名婴儿死亡。
激增的背后原因
其中一个因素就是百日咳的正常消长,这种疾病在某些年份比其他年份传播得更频繁。多伦多大学儿科传染病专家、副教授 Dr. Anna Banerji 指出,局部百日咳疫情并不罕见。
“很多细菌和病毒都是周期性的,”她说,“所以它们会一波一波地出现。”
Adalja 解释说,虽然一些病原体进化迅速,每年都会发生袭击,但百日咳的发病率往往会在三到五年的周期内出现上升和下降,这可能与人群免疫模式的变化有关,因为新的易感群体为细菌提供了引发疫情的新“火种”。
他说:“人口中总会有不具有免疫力的新生儿出生。”
这可能意味着未接种疫苗的母亲——那些在怀孕期间没有接种百日咳加强疫苗的母亲——或者没有接种全套常规疫苗的幼儿。百日咳加强疫苗可以转移对胎儿的保护。
加拿大疫苗学中心的 ElSharif 指出,疫苗或先前的百日咳感染所提供的免疫力也不能持续一生。“我们目前拥有的疫苗并不是最好的,”她说。“它们不能提供终身保护,但我们鼓励人们接种它们,因为它们在短期内确实可以提供对疾病的保护。”
虽然这些社会趋势可能可以解释百日咳通常的起伏,但多位科学家和临床医生一致认为,目前病例数量突然飙升的情况很可能是新冠疫情的又一次余震。
在疫情初期,由于各国对旅行和聚会采取了不同的反应,百日咳和流感等呼吸道疾病基本上消失了。
2022 年发表的一项回顾性研究重点关注了美国的 20 家医疗机构,发现在“新冠疫情爆发的第一年,根本没有出现百日咳”。
ElSharif 说:“疫情的根本作用是,通过自然接触获得免疫的率下降了。”
疫情限制解除后,各种感染又卷土重来。近年来,流感、呼吸道合胞病毒 (RSV) 和一种细菌性肺炎都因大规模或在异常时间再次出现而成为头条新闻——有时甚至导致加拿大和其他国家医院人满为患。百日咳似乎是最近出现的一种。
与此同时,常规免疫接种计划受到严重干扰,导致需要多年的补种。
世界卫生组织和联合国儿童基金会估计,全球三剂白喉-破伤风-百日咳疫苗的接种率从 2019 年的 86% 左右下降到 2020 年的 83%,这意味着全球有 2270 万儿童错过了接种疫苗的机会 。
在新不伦瑞克省,官员们最近警告称,百日咳疫情正在不断扩大。今年迄今为止,百日咳病例已超过 140 例,远远超过五年来 34 例的年平均值。最近,该地区儿童的疫苗接种率约为 80%——相当高,但仍然低到足以加剧百日咳的传播。
|
a
Lockdown搞得全球免疫力下降,清零论害死人
- [53] (2024-09-02 22:23:32)
|
|
b
川普那个大骗子搞得病毒武器论。他亲自关闭全世界经济
- [58] (2024-09-02 22:25:54)
|
|
c
Lockdown使中国很晚才大流行,美国不Lockdown早早就死了几百万,疫情是防不住的川普是对的
- [57] (2024-09-03 12:01:13)
|
|
b
美国医药局2019年就告诉川普,lockdown会造成环球免疫力下降了其他问题。看看报告
- [91] (2024-09-02 22:31:06)
|
|
c
"洗手、消毒和戴口罩,会降低我们对感染(包括 COVID-19)的免疫力。"
- [49] (2024-09-02 22:35:21)
|
|
d
胡说八道,医生护士在医院一辈子天天洗手消毒戴口罩,这么说医护早免疫力低都早被感染死了
- [82] (2024-09-03 11:48:10)
|
|
c
群体免疫了的减弱,使很多多年不见的怪病抬头
- [75] (2024-09-02 22:37:16)
|
|
d
是打针降低了群体免疫,21年开始打针疫情加速传播,23年没人打针了,疫情也自己停止了,疫苗对感染无用
- [62] (2024-09-03 11:33:12)
|
|
e
疫苗是川普强制FDA的头儿批的,不批就撤职
- [44] (2024-09-03 20:27:59)
|
|
a
一帮华人傻乎乎的跟着川普跑。连什么是毒品都搞不清楚
- [48] (2024-09-02 22:47:22)
|
|
b
毒品问题最严重的,都是中部那些有大型制药厂的共和党的州
- [96] (2024-09-02 22:49:51)
|
|
c
看看美国各州的毒品问题统计数据
- [87] (2024-09-02 22:53:07)
|
|
d
毒品Death Rate名列前茅的,大多是共和党的州
- [41] (2024-09-02 23:00:03)
|
|
d
毒品是共和党的问题?哈哈
- [49] (2024-09-03 11:38:05)
|
|
e
毒品问题源于里根,这都不知道
- [87] (2024-09-03 20:35:02)
|
|
e
里根把毒品责任完全推给了上当的青少年
- [47] (2024-09-03 20:37:22)
|
|
e
看看汤姆克鲁斯演的“American Made”。 演的美国毒品问题的起因
- [87] (2024-09-03 20:39:27)
|
|
f
电影直接指责了里根
- [87] (2024-09-03 20:42:01)
|
|
b
毒品问题主要是处方药问题。大麻也很毒,但比起那些处方药
- [104] (2024-09-02 23:09:42)
|
|
c
芬太尼比吗啡强100倍,比海洛因强50倍
- [83] (2024-09-02 23:16:25)
|
|
d
COVID呼吸器就要用芬太尼
- [66] (2024-09-02 23:18:38)
|
|
d
川普愚蠢地照搬了武汉失败的呼吸器治疗法
- [58] (2024-09-02 23:20:31)
|
|
d
芬太尼就是中国产的,现在的中国已经成为了毒品大出口国
- [81] (2024-09-02 23:57:47)
|
|
e
美国人买的最多
- [118] (2024-09-03 12:27:27)
|
|
e
合法非法的芬太尼是中国大厂产的,非法芬太尼是中国地下小厂产的,呼吸器也大多中国产
- [93] (2024-09-03 20:31:29)
|
|
f
川普是中国Lockdown文化最大的推销员。川普之前没一个人对中国的清零论感兴趣
- [95] (2024-09-03 20:45:17)
|